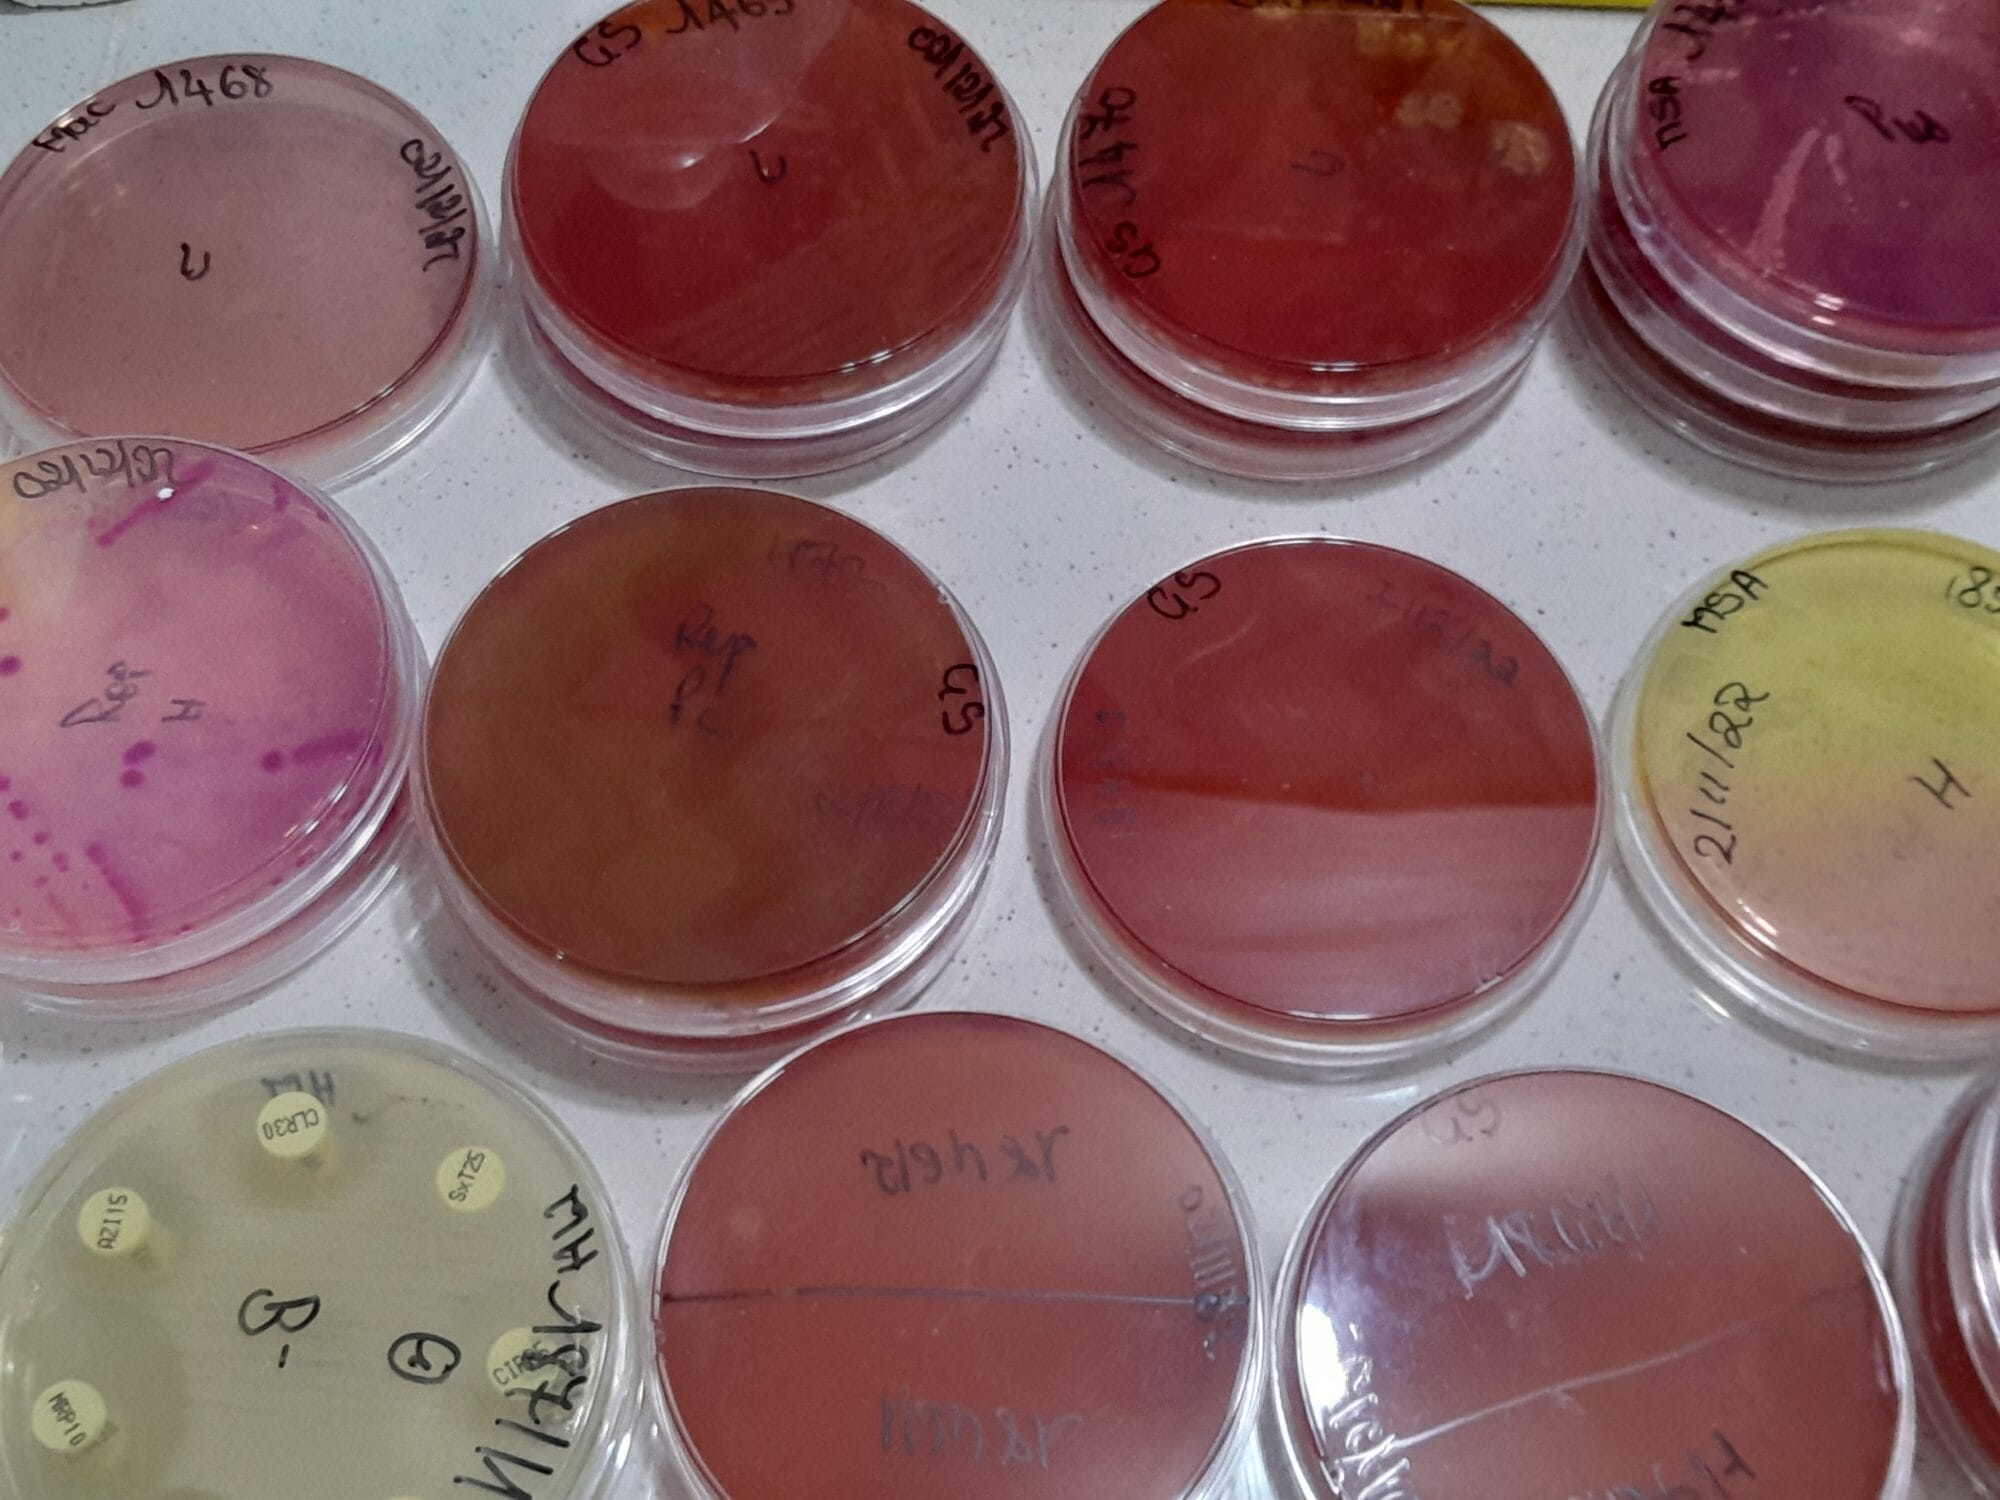

Netherlands’ Society
for Global Health
Vereniging voor global health professionals
Voorheen bekend als NVTG
Werkgroepen
Onze werkgroepen organiseren studiedagen, symposia en trainingen in binnen- en buitenland. Maak kennis met onze werkgroepen en sluit u aan.
Ontdek alle werkgroepenWie we zijn
Over NSGH
De vereniging voor Global Health professionals die zich inzet voor gelijke toegang tot zorg, in Nederland en wereldwijd. We verbinden mensen en organisaties via wetenschap, onderwijs, pleitbezorging en een sterk netwerk.
Meer informatieOnze samenwerking
Binnen onze samenwerking biedt de NSGH het netwerk voor de professionals werkzaam binnen de mondiale gezondheidszorg.
Meer informatieStrategische partners
We onderhouden nauwe contacten met andere (beroeps)verenigingen en organisaties actief op het terrein van de Global Health.
Meer informatieMedewerkers
De NSGH draait op een enthousiast team van betrokken medewerkers. Leer ons team hier beter kennen.
Meer informatieBestuursleden
Het bestuur van de NSGH geeft richting aan onze missie en activiteiten. Bekijk hier wie deel uitmaken van het bestuur.
Meer informatie